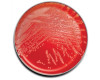

BD Microbiology Systems
-
Dehydrated Culture Media and Ingredients (0-9, A-B) -
Dehydrated Culture Media and Ingredients (C-D) -
Dehydrated Culture Media and Ingredients (E-K) -
Dehydrated Culture Media and Ingredients (L) -
Dehydrated Culture Media and Ingredients (M) -
Dehydrated Culture Media and Ingredients (N-R) -
Dehydrated Culture Media and Ingredients (S) -
Dehydrated Culture Media and Ingredients (T) -
Dehydrated Culture Media and Ingredients (U-Z)
-
BD BBL™ Paper Discs for the Detection of Beta-Lactamase Enzymes -
BD BBL™ Sensi-Disc™ Dispensers -
BD BBL™ Sensi-Disc™ Elution Discs for Susceptibility Testing of Anaerobes -
BD BBL™ Sensi-Disc™ Susceptibility Test Discs (L-Z) -
BD BBL™ Sensi-Disc™ Susceptibility Test Discs for Veterinary Laboratory Use -
BD BBL™ Sensi-Disc™ Susceptibility Test Discs (A-K) -
BD BBL™ Taxo™ Discs
-
BD BBL™ DrySlide™ Products -
BD BBL™ Specimen Collection and Transport Systems -
BD BBL™ GasPak™ Products and Accessories -
BD Diagnostic Reagents and Stain Droppers -
BD Difco™ Loops and Needles -
BD Difco™ BBL™ Stains, Droppers and Indicators -
BD Directigen™ Meningitis Test System -
BD Macro-Vue™ RPR Kits -
BD Macro-Vue™ RPR Controls -
BD Peptones / Hydrolysates